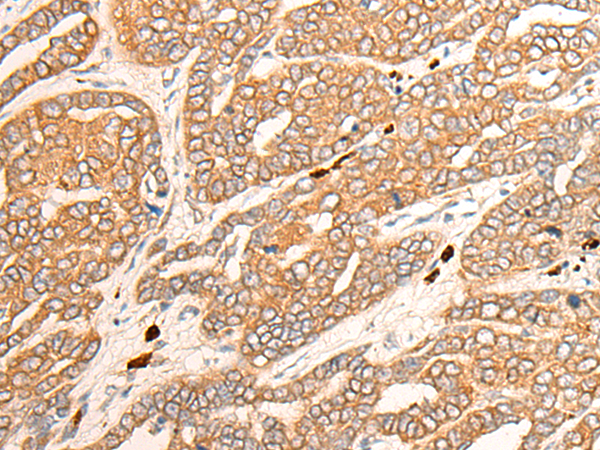
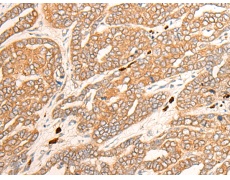
一抗

|
Background: |
This gene encodes a member of the cytochrome P450 superfamily of enzymes. The cytochrome P450 proteins are monooxygenases which catalyze many reactions involved in drug metabolism and synthesis of cholesterol, steroids and other lipids. The encoded protein has a low level of testosterone hydroxylase activity, and may play a role in aging mechanisms and cancer progression. This gene is part of a cluster of cytochrome P450 genes on chromosome 7q21.1. Alternate splicing results in multiple transcript variants encoding different isoforms. |
|
Applications: |
ELISA, IHC |
|
Name of antibody: |
CYP3A43 |
|
Immunogen: |
Fusion protein corresponding to a region derived from 304-503 amino acids of human CYP3A43 |
|
Full name: |
cytochrome P450 family 3 subfamily A member 43 |
|
SwissProt: |
Q9HB55 |
|
ELISA Recommended dilution: |
5000-10000 |
|
IHC Positive control: |
Human liver cancer; |
|
IHC Recommended dilution: |
30-150 |
購物車
購物車 幫助
幫助
 021-54845833/15800441009
021-54845833/15800441009